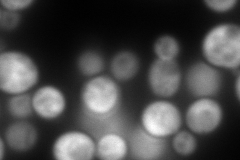
YBR137W
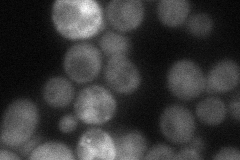
YBR137W
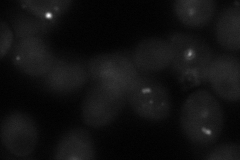
YBR137W

View description
Protein of unknown function; localized to the cytoplasm; binds to Replication Protein A (RPA); YBR137W is not an essential gene
Localization:
Intensity:
Fold change:
Significance:
-
C’ GFP library in SD

cytosol31.02 -
N' NOP1pr-GFP in SD

cytosol231.108 -
N' TEF2pr-mCherry in SD
cytosol437.249 -
N' NATIVEpr-GFP in SD
cytosol,punctate58.9098 -
N' TEF2pr-VC and Cyto-VN in SD
cytosol,punctate60.2302 -
C’ GFP library in SD+DTT

cytosol30.710.99No -
C’ GFP library in SD+H2O2

cytosol38.011.22No -
C’ GFP library in Starvation Media

cytosol34.111.09No -
C’ GFP library on the background of Pup2-DaMP

cytosol -
C’ GFP library on the background of CCT mutant

cytosol34.42221.10953No
